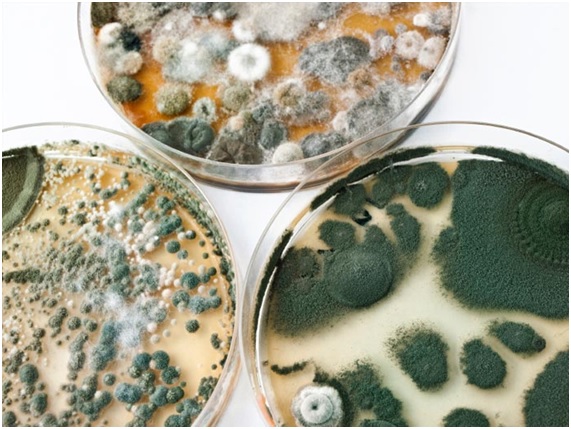
Micotoxinas y los alimentos más expuestos

Alimentos ecológicos
Extremadura concederá ayudas para la instalación de jóvenes agricultores que prevén llegar a 1.600 personas
AECOC lanza el concurso La alimentación no tiene desperdicio para favorecer el aprovechamiento de alimentos
Repuntan en Navidad las alergias a mariscos y frutos secos, así como a alimentos que reaccionan con ejercicio físico